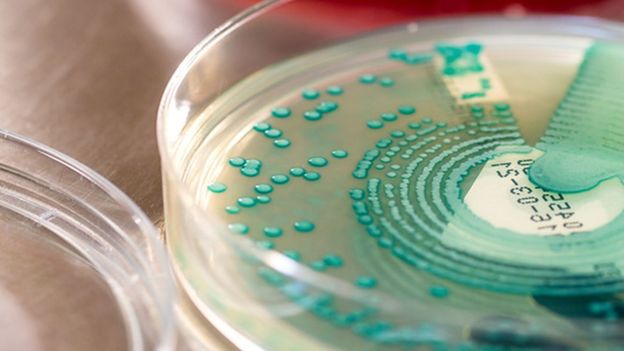

科学家发现对抗超级病菌的新希望: 塔斯马尼亚恶魔的乳汁

身为兔巴哥与达菲鸭偶尔的敌人, 狼吞虎嚥的塔斯马尼亚恶魔(袋獾)对于某个我们乐见消失的东西具有着威胁性,那家伙就是超级病菌。

澳洲的研究人员已怀疑袋獾与其它有袋动物体内带有某种特别的强效化学物质,帮助它们的下一代成长。有袋动物属于哺乳类动物,在其发育过程中极早出生,并需在母亲的育儿袋内接收哺乳数月后才能长成你我认知里毛茸茸的生物,像是袋鼠和袋貂。
澳洲是上百种土生土长有袋动物的家,包括袋獾,一种棕色或近黑色的绒毛生物,看起来近似熊宝宝,有着粗壮的腿与利齿。

就像卡通“乐一通”里的塔斯马尼亚恶魔,它们惊人的食量最广为人知。有时被称作为“森林里的吸尘器”,此世界上最大型的有袋肉食性动物捕食鸟类、蛇、鱼以及昆虫,并
将捕获物吃干抹净,包括其骨头、毛发、内脏及肉。
所谓的超级病菌即是指那些对抗生素疗程不再产生反应的细菌。 因为药物的滥用,许多细菌已经适应进化,使得药物不再像从前那么有效。 每年至少有2.3万的美国人死于相关的感染。

而引起科学家们决定进一步研究袋獾消灭超级病菌可能性的关键,并非是在于它的食量,而是它的育儿袋。 在母亲怀孕后第三周左右就出生的小袋獾们,被称之为imps,必须爬过母亲的毛发进入育儿袋,在此接受哺育与接续之后大约四个月的成长。
此时的新家环境距离无菌还有段差距。 研究显示袋獾的育儿袋内具有为数相当可观的细菌,包括对尚在发育中的幼獾会造成伤害的病原体。 科学家们猜测其母乳必具有增强免疫功能的特质,用以帮助脆弱的幼獾在那样的环境中成长。
化验母乳后科学家们发掘数种被称之为抗菌肽的多肽,是一种自然形成的抗生素。 人类系统内也拥有一种抗菌肽,但仅只一种:LL-37。 袋獾则有十二种。
此研究发表于最近一期的学术期刊文摘中。
当具有数种抗药性的细菌,如抗万古霉素肠球菌及抗甲氧西林金黄色葡萄球菌(或MRSA),在接触到袋獾乳汁中的抗菌肽时就会死亡。
此研究虽仍处于初期阶段,但针对袋獾乳汁中具有抵抗超级病菌成分的认知,可引发新药的产生。
超级病菌被视为国际保健的重大威胁,因而对于这项研究的强烈关注是可想而知。 专家相信,若没有重大突破性药物能够与之抗衡的情况下,至2050年,因抗药菌而造成的 死亡可达一千万人,或是每三秒钟即有一人。 这项消息或许也能够帮助现今被列为濒临绝种动物的袋獾,维护其族群数量,估计现有一万至二万五千只存活于野外。
此种如今只能在澳洲境内的塔斯马尼亚省岛才能看见的生物,曾经遍布于澳洲本岛。在1800年间,因牧场工人误以为袋獾捕食他们的牲畜,而在一项多方参与的行动中将它们大举于本岛歼灭。
如今袋獾最大的敌人已不是牧场工人,而是一种罕见的转移性癌症。从1990年间开始,恶魔颜面肿瘤病变已杀死数以千计的塔斯马尼亚恶魔。请不要期待袋獾奶会马上出现在附近药妆店的置物架上,因为还需要进行许多的研究实验才能看出这些多肽还有什么用处。科学家们也同时在观察其他有袋动物的家族成员,看看如无尾熊和沙袋鼠等动物的乳汁是否也能抵抗超级病菌。初期针对沙袋鼠的研究显示类似的结果。

身为遗传学者的先锋及在德州大学大河谷分校从事于另一种有袋动物,南美灰短尾袋貂,研究的John VandeBerg教授表示,真正困难的部分在于如何在临床实验中扩大复制进而得以大量生产,“但我认为可行,而且成果也许能为打击超级病菌增添一组全新的生力军。这些可能引领我们朝向极其重大的工程”

发表你的评论吧返回顶部
!评论内容需包含中文
